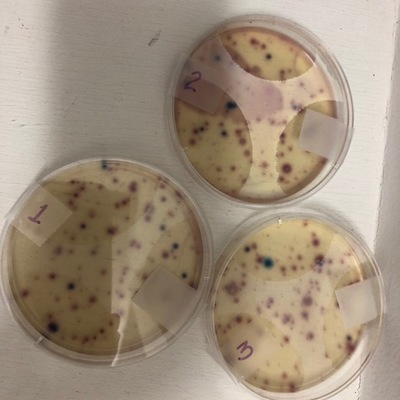

Location
Byram Swinging Bridge
Pearl River
Pearl River in Mississippi
Dataset summary
Byram Swinging Bridge has data for current_weather, other_coliform, total_coliform, incubation_time, incubation_temperature, e_coli, water_temperature, air_temperature, water_depth, river_stage, previous_weather, previous_weather_description, current_weather_description, oxygen, hardness, ph, turbidity, and alkalinity from 31 October 2018 to 14 April 2026.
- Water body type River or stream
- Dataset Mississippi Water Stewards, Mississippi State University
- Data collector Abby Braman
Data sharing
-
All datasets are open by default.
Download location data
This data is part of a bigger dataset, Mississippi Water Stewards.
- Location description
- Byram Swinging Bridge connects Hinds and Rankin counties over the Pearl River. It was added to the National Register of Historic Places in 1979. Access the river from the west (Byram) side and sample just north of the bridge. River bank is sandy but hard-packed clay near the water's edge can be slippery.